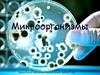
Основные группы микроорганизмов

Similar presentations:
Расчет линейного увеличения органелл. Определение фактического размера клеток с использованием микрометра и объект микрометра
1.
Расчет линейного увеличения органелл.Лабораторная работа "Определение
фактического размера клеток с
использованием микрометра и объект
микрометра".
Микрометр в технике и биологии.
2.
3.
4.
5.
6.
7.
8.
9.
10.
11.
12.
6.Определите, чему будет равен размер объекта в нанометрах, если в миллиметрах онравен 5мм.
А) 500 000 000 нм
В) 5 000 000 нм
С) 500 нм
Д) 50 000 нм
7) Определите, чему будет равен размер объекта в нанометрах, если в миллиметрах он
равен 12 мм
А) 120 мкм
Б) 12 000 000 мкм
С) 1200 мкм
Д) 12 000 мкм
8) Определите, чему будет равен размер объекта в мм, если в микрометрах он равен 30 мкм
А) 0,3 мм
В) 300 мм
С )0,03 мм
Д) 30 нм
9)Определите, чему равен размер объекта в микрометрах( мкм), если в мм его размер
равен 25 мм
А) 0,025
В) 25000
с) 0,25
Д) 250
10)Определите реальный размер объекта, если известно увеличение х200 и размер
изображения 4мм
А) 2нм
В) 50 нм
С) 20 нм
Д) 5нм
14) Каково линейное увеличение
ядра, если фактический размер
ядра составляет 30 нм, а размер на
рисунке 25 мм?
А) 1,2
В) 750
С) 83,3
Д) 833
13.
15. Каково линейное увеличение ядра, если фактический(реальный)размер ядраклетки равен 15 мкм, а размер изображения ядра измеряем линейкой из рисунка,
который равен 1,5 см.
А) 10
В) 1 000
С) 100
Д) 0,1
16)Увеличение рисунка вакуоли составляет х25000 мкм. Линейкой измеряем
размер изображения на рисунке вакуоли, который равен 19 см. Определить
фактический (реальный) размер вакуоли.
А) 0,076
В) 0,76
С) 760
Д) 7,6
17) Используя рисунок, определили точный размер данной
органеллы(митохондрия на линейке длиной 10,0 см увеличение х20 000)
А) 120 000 мкм
В) 500,0 мкм
С) 5 мкм
Д) 0,5 мкм
14.
19.Какая формула используется для расчет увеличения?(Мувеличение, I- размер клетки на микрофотографии(размерувеличения),А-реальный (фактический) размер клетки)
А) М= А*I
В) М= АI/2
С) М= А/I
Д) М= I/А
20. Вирус гриппа очень быстро может проникнуть через сухие
эпителиальные клетки носовой полости .Размер эпителиальных клеток
составляет 20 нм, размер вируса гриппа составляет 80 нм. Какое
количество вирусов может находиться в одной эпителиальной клетке у
болеющего гриппом больного?















 biology
biology